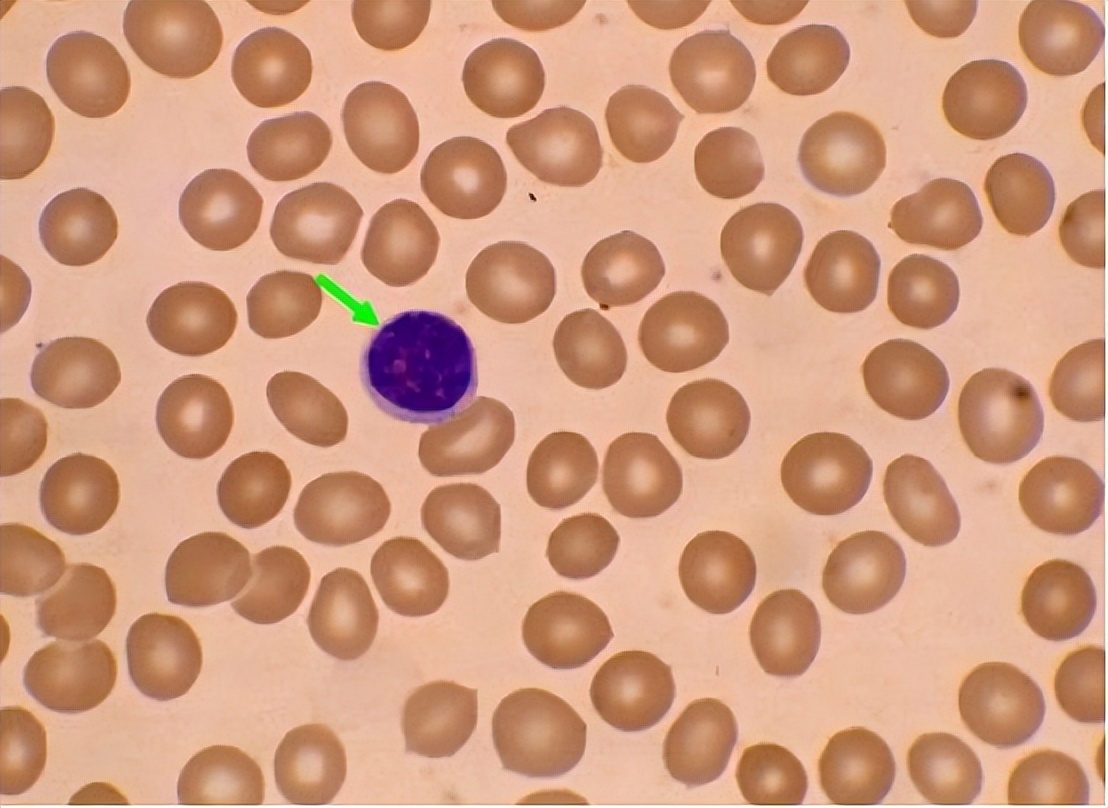
分泌性中耳炎是什么，为什么儿童得病几率更大，要怎么治疗

分泌性中耳炎是一种以中耳腔积液、传导性听力损失为主要临床特点的中耳非化脓性炎症,该病是造成儿童听力损失主要原因之一。
儿童2~7岁时发病率较高,大部分SOM是具有自限性,可在3个月内自行恢复;但仍有30%~40%患儿病情迁延或反复出现,其中5%~10%可持续发作1年以上。
最后可能引起鼓膜穿孔、胆脂瘤、鼓室硬化等并发症,造成噪声中听觉敏感性和语言识别能力下降,影响患儿的日常学习和生活。

腺样体与扁桃体一样,属于周围性(次级)淋巴器官,具有一定免疫功能,反复或慢性呼吸道感染可导致腺样体免疫屏障的组织形态和功能改变。当上呼吸道遭受自身的定植病原微生物侵袭时。
可促进机体的免疫应答,使成熟的腺样体浆细胞产生免疫球蛋白,诱导B细胞活化为成熟的B细胞和记忆B细胞,致使腺样体增生。
腺样体组织过度增生可以诱发一系列的临床表现,如:夜间打鼾、多梦易醒、鼻塞、咽部不适、张口呼吸、嗅觉和味觉能力下降、言语问题。
严重时可影响邻近器官而引发各种疾病,如SOM、慢性鼻-鼻窦炎、儿童阻塞性睡眠呼吸障碍等等。

儿童腺样体肥大引起的OSDB与SOM均是耳鼻喉科的常见病和多发病,二者存在关联。SOM起病隐匿,常因症状轻微令人难以察觉,国外已有研究表明有高达36%的腺样体肥大儿童合并有无症状的SOM。
由于儿童自我认知能力低,反馈交流能力受限等原因,儿童SOM的早期诊断往往比较困难,通常是通过被动检查发现的。
所以对于具有SOM高危因素的患儿进行早期筛查是非常必要的,可及早发现和预防可能出现的听力损失。

部分SOM患儿早期听力改变并不明显,待发现时,可能已经引起严重后果。
据统计,大概有50%SOM患儿的听力损失达到20dB,20%听力损失超过35dB,5%~10%的听力损失超过50dB;大于50dB的听力损失可能是内耳损伤所致。
SOM与许多因素相关,发病机制复杂,而各种原因导致的咽鼓管功能不良是其中的关键环节。咽鼓管具有调节鼓室气压、清洁引流、避免逆行感染、保护中耳等作用。

咽鼓管被分成外侧1/3骨部、中间峡部及内侧2/3软骨部三部分。骨部又称为原鼓室,位于颞骨内。软骨部又被称为咽鼓管的功能部,一般情况下呈闭合状态。
当产生张口、吞咽、打呵欠等动作时,咽鼓管旁肌协同作用,使管腔瞬间开放,以平衡鼓室与外界气压。当咽鼓管遭受机械性或功能性阻塞时可导致管腔开放障碍。
中耳腔负压形成并逐渐增大,鼓室内黏膜水肿增厚,上皮化生,血管扩张及通透性增加,血清漏出形成积液。SOM具有病因复杂、起病隐匿、早期诊断困难且治疗方案未标准化等特点。

一、腺样体的生理特点
腺样体又名咽扁桃体、增殖体等,是位于鼻咽腔顶部与后壁移行处的
淋巴组织,表面有4~5条纵向沟隙,而且被富含杯状细胞的假复层纤毛柱状上皮所覆盖。
它是咽淋巴环的重要组成部分,位置特殊,是呼吸道免疫防御的第一道门槛。出生后便存在,6~7岁时增生明显,10岁以后渐渐退化。主要由淋巴细胞组成。
其中50%~60%是B淋巴细胞,40%是T淋巴细胞,大约3%是浆细胞,同时具备体液免疫和细胞免疫作用。故此,儿童生长时期内行腺样体切除术当慎重考虑,以免削弱局部免疫功能。
二、腺样体增生引发SOM的发病机制
腺样体增生引起SOM的发病机制可能有以下几个方面:咽鼓管机械性阻塞或功能障碍,过度增生的腺样体淋巴组织可压迫圆枕,阻碍咽鼓管咽口的正常开放,形成中耳负压。
增生肥大的腺样体可作为病原微生物的储蓄池,逆行感染,因此鼓室积聚的渗出物通常可检测出多种病原体。当咽鼓管产生炎症反应时,其黏膜皱襞水肿或粘连,致使潴留空间减少,阻碍咽鼓管正常通气及清洁引流。
腺样体堵塞后鼻孔,导致鼻咽腔通气障碍,漏斗功能失衡,咽鼓管返流,引起咽鼓管生理功能失衡。

SOM患儿中发现腺样体肥大细胞发育异常,导致组胺和其他多种介质的释放,如白三烯、前列腺素、血小板活化因子等,继发局部炎症反应,促使中耳积液的生成。
专家等人发现,患有腺样体炎的患者长期暴露于细菌和病毒会可加重免疫反应,导致SOM的形成。
三、变应性鼻炎/鼻窦炎与SOM的关系
在解剖结构和病理生理的影响下,儿童变应性鼻炎、鼻窦炎与SOM有着极为紧密的联系。整个气道及相邻的鼻旁窦、中耳腔和喉部结构均由假复层纤毛上皮、腺上皮细胞和黏膜下腺覆盖。

黏膜纤毛清除功能可抵挡和减少致病原入侵,在气道防御中起关键性作用。SOM、腺样体肥大、上呼吸道感染和CRS等疾病可引起局部MCC疾病,这些疾病又相互促进。
腺样体周围炎症会通过化生改变和纤毛损失使得MCC功能障碍,导致鼻腔分泌停滞及分泌物排出障碍,继而感染咽鼓管和上呼吸道。腺样体切除术将通过多种机制帮助恢复正常的黏液纤毛功能。
与非过敏人群中的SOM发病率相比,过敏是较高的危险因素,可使SOM发病率提高2到4.5倍。

变态反应影响中耳炎发生的机制可能是:鼻、鼻咽部及咽鼓管黏膜上皮结构相似,当组织胺等多种介质释放时,咽鼓管黏膜受累及,组织水肿,最后导致咽鼓管狭窄、阻塞。
咽鼓管内渗出增多,表面活性物质被稀释,可提高了管腔内表面张力,减弱MCC的清洁作用,延迟中耳渗出液的排出。本文是通过追问病史及临床查体诊断的变应性鼻炎或慢性鼻窦炎。
发现腺样体肥大的同时,伴有变应性鼻炎或慢性鼻窦炎的病例中SOM发病率升高,其差异具显著意义;表明了变应性鼻炎以及慢性鼻窦炎是SOM的重要影响因素。

四、SOM的治疗方法
SOM是一种自限性疾病,其治愈率与主要病因、积液持续时间和积液性质(浆液性或黏液性)等相关。因此,一般认为发现SOM后应有3个月的观察期再行干预治疗。
SOM的保守治疗有:抗生素或其他抗菌药物治疗、口服或局部使用类固醇激素、黏液溶解促排剂、抗组胺药物、鼻减充血剂、咽鼓管吹张等,然而,是否使用及具体使用方法尚无统一定论。
儿童SOM目前常见的手术治疗方案有鼓膜穿刺术、鼓膜切开合并或不合并置管术、腺样体切除术等。

病情控制欠佳可导致积液机化和肉芽生成;而且当通气管放置的时间越长,鼓膜愈合需要的时间越长,持续性穿孔的发生率越高。
有研究表明在腺样体肥大合并SOM儿童中,相对于单纯鼓膜置管术,腺样体切除加上鼓膜置管术可加速。
五、咽鼓管扩张术
咽鼓管扩张术可通过向鼻孔充气(使用球囊或其他装置),使咽鼓管扩张,以缓解咽鼓管阻塞情况。目前主要在成人SOM的治疗上使用,有效率达91.1%。

在儿童SOM的应用相对较少,因为儿童尚且处于生长发育时期,咽鼓管功能评价标准不能确定。2017年德国的LeichtleA等报道了对经过多次手术治疗而未好转的复发性中耳炎患儿进行咽鼓管球囊扩张术,疗效良好。
因此建议其可作为常规手术治疗无效后的二线治疗方法。也有文献综述统计发现进行该治疗的患者其症状有迅速改善的趋势,然而,纯音测听和鼓室测量结果并无改善。
总之,咽鼓管扩张术有待进一步的临床试验,明确具体的实验步骤及咽鼓管功能的评定,尚不能作为SOM的一线治疗方法。

六、SOM的手术治疗
1.鼓膜置管术
指南建议在手术干预前应有3个月的观察等待。鼓膜置管术是治疗SOM的主要方法,尤其是不满4岁的儿童。其主要是在耳内镜或显微镜下进行操作,可快速有效促进鼓室渗出液排出,使鼓室与外界气压达到平衡。
然而无法短时间内缓解局部炎症,操作不慎可导致外耳道血肿、听骨链受损、鼓室粘连、永久性鼓膜穿孔等风险,不利于患儿预后,所以需要严格把握手术指征。

2.腺样体切除术
腺样体切除术可消除咽鼓管的物理阻塞,从而恢复中耳的黏液排出和正常压力,抑制病原体入侵和居住在中耳腔的能力。腺样体切除的手术器械有刮匙、电动微型切割器、低温等离子刀等。
传统手术方式术后可能造成腺样体残留过多或复发。若手术操作不当可损伤咽鼓管圆枕,导致咽口周围瘢痕粘连,阻碍SOM的好转。
电动微型切割器及内镜技术的推广,减少了手术并发症的发生。目前较为常用术式是鼻内镜下低温等离子腺样体切除术,相较于冷切术式,其可清除鼻咽部感染来源。

降低炎性因子水平,促进患儿听力恢复,降低再次置管率,值得推广。但是腺样体切除是否能缓解积液一直存在争议。
3.联合手术方式
腺样体切除术分别加上鼓膜切开术、鼓膜置管术或CO2激光鼓膜造孔术等为SOM的联合手术治疗。大多研究表示联合手术相较于单纯鼓膜置管或腺样体切除,可快速改善SOM患儿的临床症状明显提高总有效率。
可有效缩短中耳积液持续时间,降低复发率。但相对应的,其手术并发症也会增高,具体跟手术医生的临床经验及手术器械亦是相关。

总而言之,SOM的病因及发病机制、治疗方案尚且存在诸多疑问和争议,进一步研究SOM的发病机制,有利于提供针对性的治疗建议,从而规范化诊疗。
中耳黏膜的恢复,有益于缩短病程和降低复发率;但对于提高术后听力水平无明显优势。腺样体切除术通过清除局部病原微生物群,如病毒、浮游细菌和生物膜等,可减少再次置管的概率。
当腺样体肥大作为引起儿童SOM发病的主要原因时,早期切除有利于SOM的预后。

结语
有研究表明导致中耳炎反复发作的危险因素有低龄、变应性鼻炎、鼻窦炎(包括后鼻孔息肉)、反复上呼吸道感染、腺样体Ⅲ度和Ⅳ度肥大、扁桃体Ⅳ度肥大、胃食管反流、解剖及发育异常等。
临床上对于腺样体肥大合并SOM的发病机制和治疗方案尚存在诸多疑问和争议,目前未形成规范的早期预防和临床诊治的统一方案。

绝大多数学者认为当根据病因采取个体化治疗方案,因此,对腺样体与SOM的关系进行相关研究,有益于形成SOM合理规范化的诊疗方案。